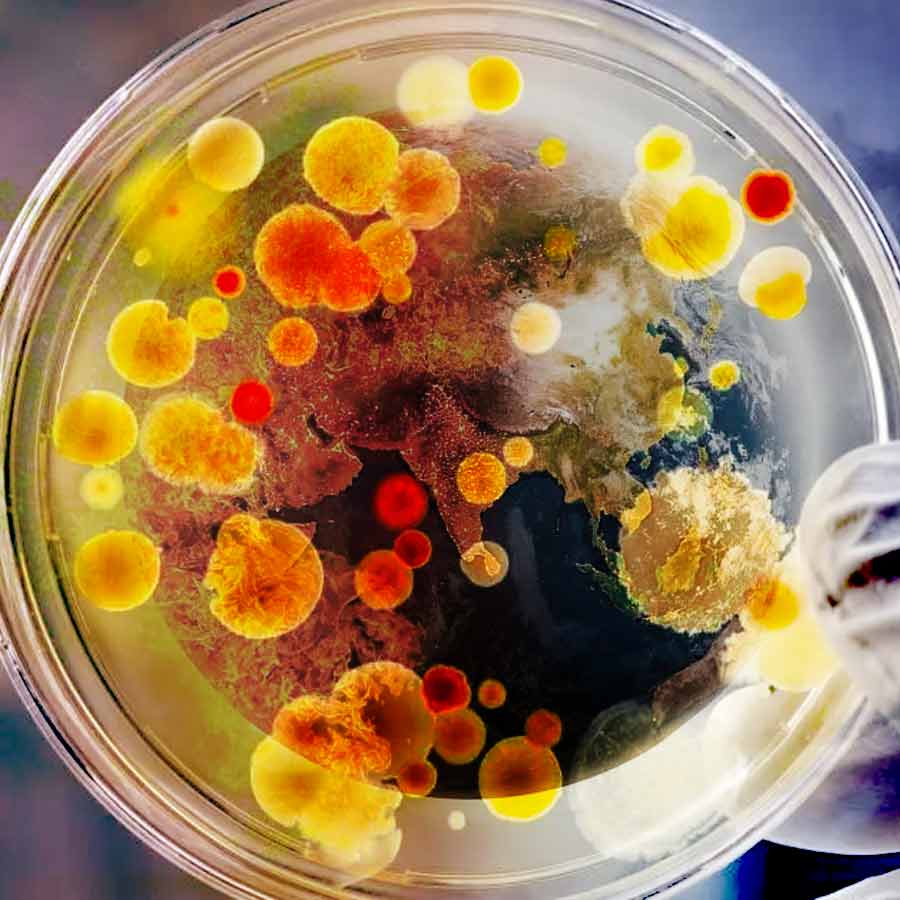
মিথেনখেকো দুই অণুজীব বিষাক্ত গ্রিন হাউস গ্যাস শুষে খায়।

এক বন্ধু শুষে নেয় মিথেন গ্যাস, অন্য জন তা থেকেই তৈরি করে ফেলে শক্তি। সমুদ্রের গভীরে এদের নিবাস। এরা একজোট হয়েই থাকে এবং মিথেন শুষে খায়। পরিবেশের ‘বন্ধু’ এমন মানিকজোড় অণুজীবের খোঁজ পাওয়া গিয়েছে। এদের বন্ধুত্বই পরিবেশকে দূষিত মিথেন গ্যাস থেকে বাঁচাতে পারে বলে আশাও রাখছেন গবেষকেরা।
পরিবেশ দূষণের কারণ শুধু কার্বন-ডাই অক্সাইড নয়। তলে তলে বিষক্রিয়া ছড়াচ্ছে আরও এক গ্রিন হাউস গ্যাস, যার নাম মিথেন। এই মিথেন কম বিপজ্জনক নয়। কৃষিক্ষেত্র থেকে, জ্বালানি পোড়ানো ধোঁয়া থেকে এরা ক্রমেই পরিবেশে ছড়িয়ে পড়ছে। যে হারে মিথেন নির্গমন বাড়ছে, তা চলতে থাকলে চলতি শতক শেষ হওয়ার আগেই পৃথিবীর গড় উষ্ণতা ৩-৪ ডিগ্রি সেলসিয়াস বাড়ার আশঙ্কাও রয়েছে। জঞ্জাল থেকে নির্গত মিথেন গ্যাস বিশ্ব উষ্ণায়নের ক্ষেত্রে কার্বন-ডাই-অক্সাইডের চেয়ে ২১ গুণ বেশি দায়ী। এমনই জানা গিয়েছে বিভিন্ন গবেষণায়। আফ্রিকা, দক্ষিণ এবং পশ্চিম এশিয়া, চিনে মিথেন নির্গমনের হার বেশি। মিথেন দূষণ কী ভাবে কমানো যায়, সে নিয়ে বিশ্ব জুড়েই বিজ্ঞানীরা মাথার ঘাম পায়ে ফেলছেন। তার মধ্যেই আশার আলো দেখা গিয়েছে।
আরও পড়ুন:
পরিবেশ বাঁচাবে মিথেনখেকো অণুজীবেরা
‘আমেরিকান অ্যাকাডেমি অফ মাইক্রোবায়োলজি’ এবং ‘আমেরিকান সোসাইটি ফর মাইক্রোবায়োলজি’-এর গবেষকেরা সমুদ্রের গভীরে বসবাসকারী ওই দুই অণুজীবের খোঁজ পেয়েছেন, একটির নাম ‘অ্যানারোবিক মিথেনোট্রফিক আর্কিয়া’ এবং অন্যটি ‘সালফেট-রিডিউসিং ব্যাক্টেরিয়া’। দুই অণুজীব প্রাকৃতিক ফিল্টারের মতো কাজ করে। জৈব-রাসায়নিক প্রক্রিয়ায় এরা মিথেন শুষে নিয়ে তাকে বিশুদ্ধ করে। ‘সায়েন্স অ্যাডভান্সেস’ জার্নালে এই গবেষণার খবর প্রকাশিত হয়েছে।

মিথেনখেকো দুই অণুজীব বিষাক্ত গ্রিন হাউস গ্যাস শুষে খায়। ফাইল চিত্র।
অ্যানারোবিক মিথেনোট্রফিক আর্কিয়া’ এক ধরনের অণুজীব যাদের কাজ হল মিথেন শুষে নেওয়া। এরা মিথেন গ্যাস টেনে নিয়ে তার উপাদানগুলিকে ছোট ছোট টুকরোয় ভেঙে ফেলে। সালফেট বা নাইট্রেটের সাহায্য নিয়ে সেই ক্ষুদ্রাতিক্ষুদ্র মিথেনের অণুগুলি থেকে ইলেক্ট্রন তৈরি করে। এই পদ্ধতিকে বলা হয় ‘অ্যানারোবিক অক্সিডেশন অফ মিথেন’। সমুদ্রের গভীরে যেহেতু অক্সিজেন নেই, তাই এরা মিথেন খেয়েই বেঁচে থাকে। এ বার অণুজীবেরা মিথেন গিলে ফেলে যে ইলেক্ট্রন তৈরি করে, সেগুলি শুষে নেয় সালফেট-রিডিউসিং ব্যাক্টেরিয়ারা। তারা ওই ইলেক্ট্রন থেকে শক্তি তৈরি করে পরিবেশে ফিরিয়ে দেয়। এই পদ্ধতি চক্রাকারে চলতে থাকে। ফলে যেখানে এই মানিকজোড়েরা থাকে, সেই অঞ্চলে মিথেন গ্যাসের মাত্রা প্রায় শূন্যে নেমে আসে।
গবেষক ভিক্টোরিয়া অরফ্যান জানাচ্ছেন, এই দুই অণুজীবকে কী ভাবে পরিবেশ শোধনের কাজে লাগানো যায়, সে চেষ্টা চলছে। কী ভাবে এরা একজোট হয়ে গ্রিন হাউস গ্যাস শুষে নিচ্ছে, সে পদ্ধতি পুরোপুরি আয়ত্তে এলে, দূষণ নিয়ন্ত্রণে রাখার কোনও অভিনব পন্থা খুঁজে পাওয়া সম্ভব হবে।











